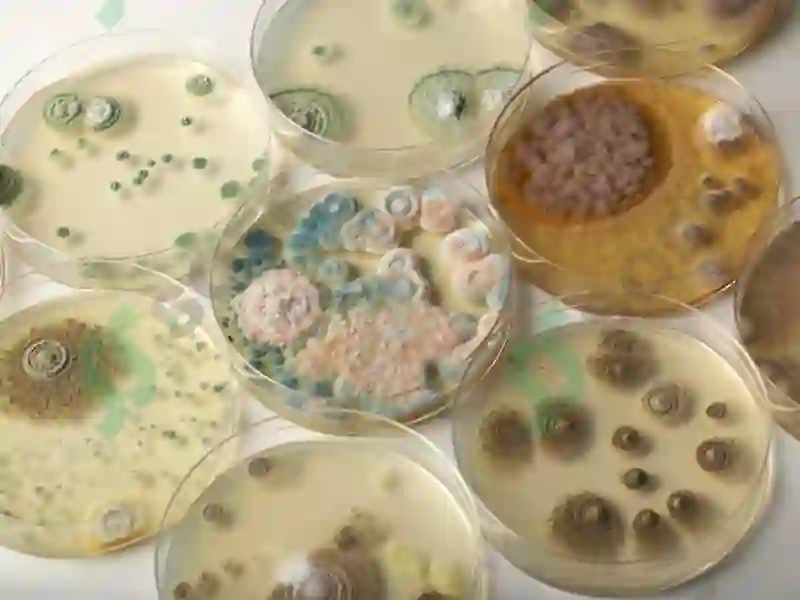
Preview 6

37
Premium Content
Oziq-ovqat mahsulotlari
1 ta sotilgan
5,000so'm
Sotuvlar soni
1 taBetlar soni
34 taFayl hajmi
2.65 MBFayl turi
.pptxMahsulot tavsifi
Oziq-ovqat mahsulotlarining kasalliklar, intoksikatsiyalar va sanitarbaholashdagi ahamiyati.
Teglar
#kasalliklar#intoksikatsiyalar#sanitarbaholash
Premium Content
Oziq-ovqat mahsulotlari
1 ta sotilgan
5,000so'm
Sotuvlar soni
1 taBetlar soni
34 taFayl hajmi
2.65 MBFayl turi
.pptx
✓
Muallif
ONLY PPT & PPTX
Tasdiqlangan sotuvchi
Jami mahsulotlar15648 ta
Sotilgan812 ta